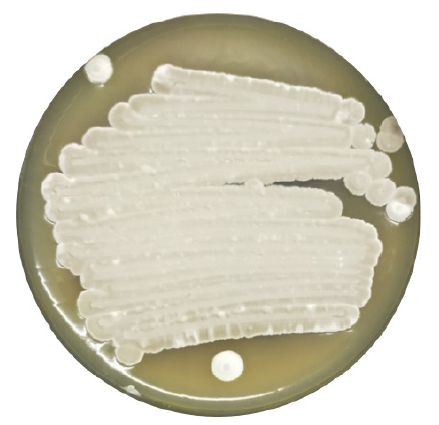
Cover Image

Published:
2023-03-31
Full Issue
Original Research
-
HTML : 1038 | PDF : 641 | XML : 0 |
-
HTML : 911 | PDF : 447 | XML : 0 |
-
HTML : 742 | PDF : 415 | XML : 0 |
-
HTML : 686 | PDF : 438 | XML : 0 |
-
HTML : 827 | PDF : 373 | XML : 0 |
-
HTML : 716 | PDF : 356 | XML : 0 |
-
HTML : 594 | PDF : 308 | XML : 0 |